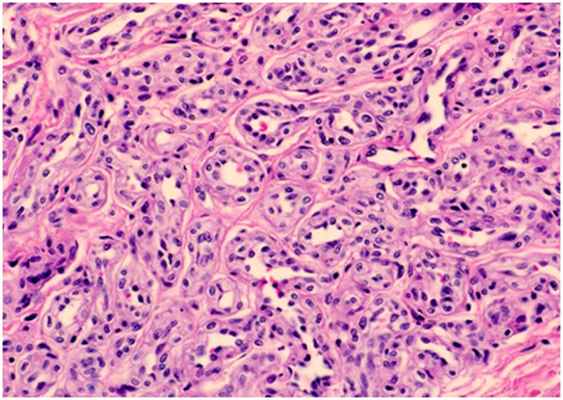
Глубоко залегающие сосуды - гистологическая картина гемангиомы

Капиллярная мальформация
Добавил пользователь Алексей Ф. Обновлено: 01.11.2025
БЕСПЛАТНАЯ КОНСУЛЬТАЦИЯ: поможем врачам и владельцам клиник выбрать оборудование для удаления сосудов
Оглавление
Глубоко залегающие сосуды представляют собой патологически измененные капилляры, питающие гемангиомы и мальформации, а также увеличенные венулы, залегающие в коже на глубине до 5 мм.
В нашей компании Вы можете приобрести следующее оборудование для удаления глубоко залегающих сосудов:
К состояниям, при которых в коже присутствуют глубоко залегающие сосуды, относятся следующие:
- Инфантильные гемангиомы
- Капиллярные гемангиомы
- Кавернозные гемангиомы
- Сосудистые мальформации
- Варикозное расширение вен
Этиология и патогенез
Младенческие (инфантильные) гемангиомы
Являются наиболее распространенными сосудистыми опухолями у детей — они встречаются у 3–10% новорожденных со светлой кожей. Ни причины, ни конкретные клетки, из которых происходят инфантильные гемангиомы, на сегодняшний день окончательно не установлены. На этот счет имеется много теорий, в которых «подозревается» плацентарная ткань, эндотелиальные клетки-предшественники и мезенхимальные стволовые клетки.
Есть данные о том, что в течение третьего триместра беременности незрелые эндотелиальные клетки плода сосуществуют с незрелыми перицитами, которые сохраняют пролиферативную активность в течение ограниченного периода времени после родов. Ангиогенные пептиды (факторы роста фибробластов и эндотелия сосудов) стимулируют деление этих незрелых клеток, что приводит к развитию гемангиомы. По мере дифференцировки эндотелиальных клеток начинается приток тучных и миелоидных клеток, а также тканевых ингибиторов металлопротеиназ (ТИМП). Вместе они останавливают деление и запускают инволюцию гемангиомы.
Инфантильные гемангиомы состоят крупных и активно пролиферирующих клеток сосудистого эндотелия. В начале пролиферации они беспорядочно скапливаются в определенной области, но со временем организуются в особые сосудистые пространства с каналами, заполненными клетками крови (рис. 1). Поскольку инфантильные гемангиомы являются доброкачественными образованиями, они не могут делиться бесконечно. Со временем активность этого процесса начинает угасать, и гемангиомы приобретают дольчатую структуру. На замедление пролиферации влияют тучные клетки — они же участвуют в распространении питающих опухоль артериол и венул.
Рис. 1. Гистологическая картина инфантильной гемангиомы с крупными эндотелиальными клетками в дермальном слое кожи (Medscape)
Капиллярные гемангиомы
Часто встречающиеся доброкачественные опухоли орбиты и периорбитальной области у детей. Они состоят из эндотелиальных клеток и характеризуются быстрым ростом с последующей спонтанной инволюцией (рис. 2). Это отличает капиллярные гемангиомы от сосудистых мальформаций, которые сохраняются и у взрослых.
Считается, что капиллярные гемангиомы имеют плацентарное происхождение. Обычно они демонстрируют две фазы роста — пролиферативную и инволютивную. Пролиферативная фаза характеризуется быстрым ростом опухоли и длится от 8–18 месяцев и более. При этом увеличивается число эндотелиальных и тучных клеток — последние стимулируют рост питающих гемангиому сосудов.
Инволютивная фаза характеризуется медленной регрессией гемангиомы — около 50% опухолей исчезают к 5 годам, а 75% — к 7 годам. В это время количество тучных клеток снижается до нормы, и наблюдается уменьшение активности эндотелиальных клеток.
Рис. 2. Гистологическая картина капиллярной гемангиомы с характерными дермальными кластерами, в которых видны тонкостенные капилляры (Ilovepathology)

Кавернозные гемангиомы
Являются результатом образования сосудистых каналов в окружающих мягких тканях (рис. 3). Локальное изменение гемодинамики способствует появлению новых сосудов у данной опухоли, что позволяет ей распространяться еще больше. На границе кавернозной гемангиомы с нормальными тканями появляется фиброзная капсула. Возможно нарушение зрения из-за сдавления зрительного нерва, глазных мышц или окружающих сосудов.
Рис. 3. Гистологическая картина кавернозной гемангиомы с обширными пространствами, заполненными кровью (Ilovepathology)

Сосудистые мальформации
Наиболее распространенной капиллярной мальформацией является винное пятно (врожденная капиллярная ангиодисплазия, пламенеющий невус). Оно присутствует сразу после рождения ребенка и увеличивается пропорционально его росту (рис. 4). Его отличительной особенностью является отсутствие спонтанной регрессии. Иногда возможно появление винного пятена на коже во взрослом возрасте (приобретенная капиллярная ангиодисплазия).
Рис. 4. Капиллярная мальформация у 3-месячного ребенка с винным пятном на щеке — видны случайно расположенные капилляры в папиллярной дерме (Merrow C., et al. Revised classification of vascular lesions from the International society for the study of vascular anomalies: Radiologic-pathologic update. Radiographics 2016; 36(5): 150197)

Венозные мальформации встречаются у 1–4% детей — как и капиллярные мальформации, они присутствуют с рождения. Венозные мальформации состоят из массы небольших венул, каждая из которых имеет стенку толщиной в один слой эндотелиальных клеток. Эти венулы хаотично переплетаются между собой, образуя неупорядоченную структуру (рис. 5). Такие мальформации растут пропорционально росту ребенка, однако могут значительно увеличиваться в период полового созревания, гормональных изменений или при возникновении инфекции.
Рис. 5. Гистологическая картина венозной мальформации (а) и венозной мальформации с интраваскулярной эндотелиальной гиперплазией (b) (North P. E Histology of vascular malformations. In: Mattassi R., Loose D., Vaghi M. (eds) Hemangiomas and vascular malformations. Springer, Milano 2015)

Лимфатические мальформации представляют собой переплетения однослойных сосудов и везикул, заполненных лимфатической жидкостью (рис. 6). Около 75% мальформаций возникают на шейно-лицевой области. В прошлом их называли лимфангиомами, что является неверным, поскольку в данном случае отсутствует клеточная гиперплазия. Лимфатические мальформации никогда не регрессируют, но могут расширяться и сжиматься в зависимости от объема лимфы, наличия травмы, воспаления и других факторов.
Рис. 6. Гистологическая картина лимфатической мальформации (Pathology Outlines)

Варикозное расширение вен
Это внешнее проявление хронической венозной недостаточности, которая связана с нарушением обратного тока крови от конечностей к сердцу. Мягкие формы (венозные телеангиэктазии) вызывают только косметические дефекты, тогда как тяжелые формы могут приводить к образованию язв, некрозу и нарушению питания конечности.
Варикоз зафиксирован у 23% взрослого населения, а если учитывать легкие формы заболевания, показатель возрастает до 80% у мужчин и 85% у женщин. Среди его причин стоит упомянуть повышение давления в поверхностных венах, слабость клапанного аппарата и венозных стенок, беременность и длительное стояние на ногах.
Клинические проявления
Младенческие (инфантильные) гемангиомы
Самым ранним признаком детской гемангиомы является побледнение участка кожи (возможно с мелкими телеангиэктазиями), которое в дальнейшем трансформируется в красное или малиновое пятно (рис. 7). Характерным признаком является быстрый рост опухоли в первые 4 недели жизни ребенка. Обычно она растет быстрее самого новорожденного, что отличает ее от сосудистых мальформаций, которые увеличиваются пропорционально росту младенца.
Инфантильная гемангиома может становиться выпуклой или куполообразной, приобретать дольчатую структуру или оставаться плоской. В течение первого года жизни ребенка идет фаза пролиферации опухоли, при этом наибольшее ее увеличение фиксируется в первые 4–6 месяцев.
Инволютивная фаза младенческой гемангиомы может быть короткой или длительной, причем заранее предугадать это невозможно. Но достоверно известно, что из всех поражений, которые разрешились к 6 году жизни ребенка, 38% оставляют после себя рубцы, телеангиэктазии или анетодермичную (атрофичную) кожу. Если гемангиома разрешается после 6 лет, указанные остаточные явления фиксируются в 80% случаев. Также замечено, что инфантильные гемангиомы, которым требуется больше времени для развития, имеют более высокую частоту остаточных кожных явлений.
Рис. 7. Инфантильная гемангиома на лбу (а), волосистой части головы (b), щеке (c) и верхней губе (d) (Itinteang T., et al. Biology of infantile hemangioma. Frontier Surg 2014; 1)

Капиллярные гемангиомы
Обычно это красные пятна прогрессирующих размеров в периорбитальной области. Гемангиомы при надавливании белеют, в отличие от винных пятен, цвет которых не меняется. Из-за выраженного объема опухоли ребенок может быть не в состоянии открыть пораженный глаз (рис. 8). Характерно снижение остроты зрения на затронутой стороне — амблиопия наблюдается у 43–60% пациентов.
Рис. 8. Капиллярная гемангиома на нижнем веке (Kavoussi S.C., et al. Spontaneous periocular ecchymosis in children: Differential diagnosis and current trends in evaluation and manangement. J Clin Exp Ophthalmol 2014; 5: 1–10)

Кавернозные гемангиомы
Являются глубоко залегающими в коже новообразованиями, которые проявляются голубоватой припухлостью на руке или другой области тела (рис. 9). Могут иметь небольшой диаметр или достигать крупных размеров.
Рис. 9. Кавернозная гемангиома в периаурикулярной области (Skintags Removing)

Сосудистые мальформации
Винное пятно (капиллярная мальформация) сперва выглядит как светло-розовая или розовая область, которая при ближайшем рассмотрении состоит из отдельных сосудистых веточек. Большинство мальформаций располагаются на лице или шее, в 45% занимая от 1 до 3 областей, иннервируемых тройничным нервом, а в 55% могут переходить на противоположную сторону лица.
По мере роста ребенка винное пятно увеличивается в размерах, становясь светло-красным или полностью красным (рис. 10). При этом оно выглядит как сплошная сеть сосудов, где невозможно выявить отдельные ветви. Возможно озлокачествление винного пятна с перерождением в раковую опухоль.

Венозные мальформации выглядят как мягкие образования голубоватого цвета, обычно возникающие на лице, нижних конечностях или туловище (рис. 11). Они представляют собой зависимые поражения, т.е. расширяются и сжимаются в зависимости от положения пациента. Венозные мальформации предрасположены к тромбозу, в результате чего возникают флеболиты, которые в данном случае являются патогномоничным симптомом.
Лимфатические мальформации возникают с рождения и проявляются в виде маленьких куполообразных узелков красноватого цвета из-за небольших кровотечений. По размеру лимфатических камер их делят на макроцистные (> 2 см), микроцистные (рис. 12), приводя к деформации костей и обезображиванию лица ребенка.
Рис. 11. Венозная мальформация на лице (Craniofacial team of Texas)

Рис. 12. Лимфатическая мальформация на шее (Dr. P. Marazzi/Science Photo Library)

Варикозное расширение вен
Клинические проявления крайне разнообразны — от небольших венозных телеангиэктазий («сосудистых звездочек») до объемных выпячиваний крупных вен под кожей, с язвами и некрозом. Если говорить о легкой степени болезни, которую можно вылечить нехирургическим путем, венозные телеангиэктазии подразделяют на древовидные (ветвящиеся), паукообразные (звездчатые), линейные (простые), пятнистые (пантиформные). В отсутствие терапии они постепенно распространяются по коже (рис. 13), после чего могут поражаться крупные и глубокие сосуды с присоединением различных осложнений.
Рис. 13. Телеангиэктазии на бедре (Primary Care Dermatology Society)

Принципы лечения глубоких сосудов
Выбор метода лечения должен начинаться с тщательной оценки состояния пациента. На основании этого следует определить, может ли тот или иной метод решить выявленную проблему.
Для лечения глубоких сосудов, в том числе питающих гемангиомы и мальформации, может применяться склеротерапия — введение в сосудистый просвет особого вещества, которое вызывает деструкцию эндотелия с последующим образованием тонкого фиброзного тяжа. Таким образом можно устранять сосуды диаметром от 4 мм и более.
«Золотым стандартом» удаления мелких поверхностных сосудов с глубиной залегания до 5 мм является Nd:YAG лазер 1064 нм. Его излучение обладает оптимальной глубиной проникновения и хорошо поглощается гемоглобином крови. Процедуры лазерной терапии проводятся без нарушения целостности кожных покровов, хорошо переносятся и не требуют длительной реабилитации. Nd:YAG лазер может сочетаться со склеротерапией или хирургическим удалением крупных и глубоко залегающих сосудов.
В случае глубоких сосудов они часто оказываются «накрытыми» сетью поверхностных капилляров, которая забирает часть лазерного излучения. Поэтому для эффективной терапии используется комбинация интенсивного импульсного света (IPL) и Nd:YAG лазера 1064 нм. Оба этих модуля входят в универсальную платформу М22 от Lumenis.
Капиллярная мальформация
Капиллярная мальформация (КМ) это порок развития, который выглядит как плоское красно-розовое пятно с четкими географическими краями. Обычно оно располагается на лице или шее, реже на других участках тела.
Что это такое?
Если приглядеться к дефекту под микроскопом, то можно увидеть, что оно состоит из множества расширенных капилляров. В народе его называют “винным пятном” за характерный оттенок.
У новорожденных мальформация часто имеет розоватый оттенок. С возрастом может становится темнее. Да, к сожалению, не нужно надеяться, что “винное пятно” самопроизвольно уменьшится, станет светлее или исчезнет. Это косметический дефект, который без специального лечения может сопровождать человека на всем протяжении жизни.
Причины появления
Примерно 1 ребенок из 330 появляется на свет с капиллярными мальформациями[1]. Иногда их рассматривают как симптом врожденного заболевания (например, синдрома Стердже-Вебера, Клиппеля-Треноне, Сервелла-Мартореля или микроцефалии с мальформациями)[2]. Но чаще всего, они являются изолированным косметическим дефектом без сопутствующей симптоматики.
Что делать?
50% всех капиллярных мальформаций локализуются в области лица и шеи. И поэтому первый вопрос, который задают на приеме родители: “Как нам избавиться от пятна?”.
Еще пару десятилетий назад доктора развели бы руками, сказав, что внешность это не главное. Однако, с годами отношение к “винным пятнам” изменилось. Сейчас их рассматривают не только как эстетическую проблему, а как источник физического и психологического дискомфорта, влияющего на качество жизни, выбор профессии и партнера.
Поэтому первым шагом для коррекции “винного пятна” является поиск профессионального детского сосудистого хирурга, который специализируется на лечении капиллярных мальформаций.
Как происходит лечение? Не вреден ли лазер для ребенка?
Современным способом лечения капиллярных мальформаций является импульсная лазерная терапия с красителем (лазерная фотокоагуляция). Лазеры используют длину волны 532 и 1064 нм, воздействуя импульсами короткой продолжительности.
В “Азбуке здоровья” коррекция капиллярный мальформаций проходит на американском сосудистом лазере Cuteta Excel V. Его главной особенностью является сверхчеткое расположение точки приложения энергии. Благодаря этому, идет работа на сосудистой ткани, окружащие ткани не травмируются, а на коже не остаются рубцы.
Во время процедуры ребенок чувствует легкое покалывание в области действия лазера, похожее на укусы комара или ожог от крапивы. Обычно обезболивание не требуется. В течение 20-30 дней после лечения мальформация постепенно бледнеет.
Исчезнет ли пятно полностью?
Дать ответ на этот вопрос сможет только доктор на приеме. Ответ зависит от:
● Локализации пятна (кисти, стопы и кожа в области носогубного треугольника сложнее поддаются осветлению);
● Возраста пациента: чем моложе ребенок, тем легче проходит процедура;
● Характеристики самого пятна: толщины и диаметра сосудов;
● Особенностей лечения: алгоритм и количество процедур назначает врач, от дисциплины пациентов зависит результат. Наилучшие показатели были достигнуты при 4-8 сеансах воздействия[4].
Обычно врачи предпреждают, что полного удаления пятна не всегда удается достичь. Но показатели осветления пятна на 70-80% обычно считаются успехом и удовлетворяют пациентов[5].
К сожалению попрощаться с доктором после процедуры навсегда тоже не получится. Мы рекомендуем продолжать наблюдение в течение нескольких ближайших лет после операции, поскольку иногда у пациентов происходит рецидив по неизвестным причинам.
Капиллярная мальформация - симптомы и лечение
Что такое капиллярная мальформация? Причины возникновения, диагностику и методы лечения разберем в статье доктора Сафина Динара Адхамовича, сосудистого хирурга со стажем в 14 лет.
Над статьей доктора Сафина Динара Адхамовича работали литературный редактор Маргарита Тихонова , научный редактор Сергей Федосов и шеф-редактор Лада Родчанина
Определение болезни. Причины заболевания
Капиллярная мальформация — это врождённый порок развития капилляров кожи, который возникает из-за случайной мутации, не связанной с наследственностью. Данный генетический дефект приводит к появлению избыточного количества сосудов в коже, иногда нарушает связь поражённой области с нервной системой . Причём диаметр избыточных сосудов больше, чем у нормальных капилляров.

Капиллярная мальформация встречается у 0,3-0,5 % новорождённых, т. е. у 3-5 детей на 1000 новорождённых [2] [3] [4] . Одинаково часто возникает у мальчиков и девочек.
Понятие "капиллярная мальформация" включает в себя комплекс различных заболеваний и состояний. Всем им характерен порок развития капилляров кожи и их изменения. К таким заболеваниям относят "винное пятно" , капиллярную ангиодисплазию , невус Унна и др. [1] . По сути, данные изменения являются вариациями капиллярной мальформации.
По такому же принципу, из-за сходства с цветом красного вина, получило своё название и "винное пятно" — "portwine stain", или сокращённо PWS. Данный термин до сих пор используется в западной медицинской литературе, в том числе и в научной.

Термин "капиллярная ангиодисплазия" наиболее распространён в отечественной медицинской литературе. В переводе с древнегреческого языка он означает неправильное формирование сосудов. По сути, такой термин включает более широкий круг заболеваний, сопровождающихся различными патологиями капилляров.

Невус Унна — это капиллярные пятна, возникающие на коже у новорождённых в области лба, между бровей, верхних век, носа, верхней губы и затылка. Данные пятна появляются из-за внутриутробного сдавления кожи между крестцом матери и костями черепа ребёнка. Капилляры за счёт длительного давления становятся более широкими и распластанными, но постепенно тонус капиллярной стенки нормализуется и цвет становится менее интенсивным.
Встречается невус Унна более чем у 50 % белокожих новорождённых детей [1] . Иначе его называют "поцелуем ангела", если пятна располагаются в области лба, век, носа, верхней губы, или "укусом аиста", если пятна располагаются в области затылка, а также лососевым и затухающим капиллярным пятном.

Пламенеющий невус — устаревшее название капиллярной мальформации. Данное название болезни появилось из-за ярко-красной окраски некоторых пятен, похожих на цвет пламени. Сейчас такой термин не используется.
При обнаружении схожих симптомов проконсультируйтесь у врача. Не занимайтесь самолечением - это опасно для вашего здоровья!
Симптомы капиллярной мальформации
Для капиллярной мальформации характерно наличие пятна от бледно розового до фиолетового цвета. Располагается пятно на уровне кожи, иногда возвышается над ней в виде "булыжной мостовой".
Интенсивность цвета может меняться в течение дня, к примеру утром светлее, вечером темнее. Яркость пятна повышается при подъёме температуры тела или окружающей среды, во время физической нагрузки или кормления ребёнка. Но эти изменения носят обратимый характер: когда воздействие раздражающего фактора прекращается, пятно приобретает свой обычный цвет.
По размеру мальформация бывает разной: от небольшого пятнышка до обширного пятна, которое занимает половину лица, шеи, туловища, распространяется на руки и ноги. Причём это может быть как сплошное пятно, так и мозаичное, с участками здоровой непоражённой кожи.

Наиболее частая локализация капиллярной мальформации — область лица и шеи [4] . Пятно может располагаться на любом участке лица и занимать различную площадь, переходя на волосистую часть головы, ушную раковину и слизистую оболочку рта.
Для пятна на лице характерен интенсивный цвет. Для пятна на лице характерен интенсивный цвет. При этом у 55-70 % пациентов отмечается разрастание мягких тканей (чаще вовлекаются губы), у 22-45 % — разрастание костной ткани (чаще верхней челюсти) и у 18 % — локализованные поражения кожи на пятне, например пиогенные гранулёмы — мясистые сосудистые узелки [5] .

В ряде случаев при определённом расположении пятна на лице можно заподозрить синдром Штурге — Вебера. В этом случае помимо винного пятна могут наблюдаться неврологические расстройства, например судороги, очаговый неврологический дефицит и умственная отсталость [13] .

При расположении капиллярной мальформации на туловище или конечностях пятно, как правило, имеет бледно розовый цвет. С течением времени такая мальформация светлеет или наоборот темнеет до фиолетового цвета. Чаще такое происходит с пятнами на коже ног.
По мере взросления цвет и размер капиллярной мальформации медленно меняются. Как правило, с возрастом пятно темнеет, становится розовым или красным.

Поскольку капиллярная мальформация расположена в дерме и не имеет тенденцию к разрастанию, основной жалобой пациента будет стойкий косметический дефект, который может спровоцировать развитие депрессии и навязчивых состояний.
Патогенез капиллярной мальформации
Капиллярная мальформация — это врождённый порок развития сосудов. Появление данной патологии связано с возникновением случайной мутации в определённых генах [5] .
Такие генетические изменения не связаны с передачей по наследству. Эти мутации возникают на ранних этапах образования и развития эмбриона.
Некоторые причинные мутации уже выявлены [6] , но для ряда капиллярных мальформаций такие генетические изменения не определены. Например, у пациентов с невусом Унна специфические мутации не установлены. А для простых капиллярных мальформаций, в том числе и при синдроме Штурге — Вебера, выявлена случайная мутация в гене GNAQ, также возможны изменения в гене GNA11.
При сочетании капиллярной мальформации с другими патологиями наблюдаются изменения в других генах:
- при сочетании с артериовенозной мальформацией (АВМ) характерны изменения в гене RASA1 или EPHB4;
- при сочетании с микроцефалией — изменения в гене STAMBP;
- при сочетании с увеличением головного мозга и дефектом коры в виде мелких неглубоких извилин — изменения в гене PIC3CA.

При врождённой геморрагической телеангиэктазии — синдроме множественных сосудистых мальформаций — в зависимости от типа определяются изменения в трёх генах:
- 1 тип — ENG;
- 2 тип — ACVRL1;
- 3 тип — SMAD4.
Нарушение закладки капилляров в дерме приводит к появлению расширенных сосудов. Выдвигались теории о том, что иннервация таких сосудов нарушается, особенно при расположении пятна на лице — в зоне иннервации тройничного нерва. Однако при расположении пятна на других участках тела признаки нарушения иннервации не наблюдаются.
Классификация и стадии развития капиллярной мальформации
Наиболее удобная классификация сосудистых аномалий создана Международным обществом по изучению сосудистых аномалий (ISSVA) [7] . Она постоянно дополняется новыми нозологиями и уточняется. Сейчас в этой классификации выделены следующие виды капиллярной мальформации:
- простая;
- сочетающаяся с другими видами сосудистых аномалий: капиллярно-венозная, капиллярно-лимфовенозная, капиллярно-артериовенозная;
- в составе синдромов, например синдрома Штурге — Вебера и синдрома Клиппеля — Треноне. Первый синдром сопровождается поражением кожи, глаз, нервной системы и внутренних органов. Характеризуется наличием капиллярной мальформации на коже лица, ангиомой сосудистой оболочки мозга и мягкой мозговой оболочки. Синдром Клиппеля — Треноне является редким врождённым заболеванием, при котором нарушается формирование кровеносных и лимфатических сосудов, кожи, мышц и костей. Сопровождается появлением винного пятна, пороками развития вен, разрастанием мягких тканей и костей.

Хотя классификация ISSVA удобна в использовании, она не отображает всю полиморфность капиллярных мальформаций. Её следует дальше структурировать и дополнять.
Осложнения капиллярной мальформации
С возрастом цвет капиллярной мальформации может перейти к красным или бордово-фиолетовым тонам. Часто такое изменение совпадает с утолщением кожи в области пятна [4] [8] . Данный феномен можно объяснить постепенным увеличением диаметра капилляров, которое увеличивает застой крови в зоне пятна. Возникает патологический круг: увеличение диаметра и количества сосудов приводит к усилению кровотока, в свою очередь активный кровоток стимулирует появление новых капилляров. Постепенно участок поражённой кожи утолщается и деформируется.

Активный кровоток в толще кожи приводит к появлению различных новообразований на поверхности капиллярной мальформации. Такие образования вынесены в отдельную группу — CEAN (cutaneous epithelioid angiomatous nodule), т. е. кожные эпителиоидные ангиоматозные узелки. Данная группа включает в себя редкие доброкачественные сосудистые новообразования, в состав которых входят гистиоциты — это эндотелиальные клетки, которые в основном находятся в дерме или под кожей. Такая группа опухолевидных образований впервые была описана итальяно-американским доктором J. Rosai в 1979 году [9] .
Кровотечение как осложнение не характерно для капиллярной мальформации из-за небольшого диаметра патологических сосудов. При порезе или другом повреждении кожи в области капиллярной мальформации не будет сильного кровотечения, оно остановится самостоятельно. Но следует помнить, что частое травмирование кожи, например при бритье, может спровоцировать появление кожных аденоматозных эпителиодных узелков на поверхности мальформации.
Диагностика капиллярной мальформации
Для постановки диагноза при простой капиллярной мальформации достаточно осмотра врача, который занимается лечением этой болезни. Проведения инструментальных или лабораторных исследований для такой формы патологии не требуется [5] . Но при сочетании мальформации с другими сосудистыми аномалиями или синдромами необходимо дополнительное обследование с участием команды врачей: педиатра, хирурга, ортопеда, генетика, онколога, специалиста лучевой диагностики, окулиста и дерматолога.
Одним из методов обследования, которые позволяют достоверно визуализировать капиллярную мальформацию, является дерматоскопия — визуальный осмотр кожи через прибор с большим увеличением.

МРТ позволяет определить наличие сосудистого компонента в мягких тканях. В случае простой капиллярной мальформации такие изменения незначительны, поэтому информативность такого исследования минимальная. Учитывая, что у детей младшего возраста это исследование проводится под наркозом или седацией, рутинно выполнять МРТ детям не рекомендуется. Показаниями к МРТ служат: сочетанные формы сосудистых мальформаций и синдромальные формы заболевания, например синдром Штурге — Вебера.
Проведение КТ или МСКТ (мультиспиральной КТ) обязательно при подозрении на распространение патологических процессов на костные структуры, которые сопровождаются их утолщением или деформацией. При сочетанных сосудистых аномалиях и подозрении на проникновение патологических сосудов в костные структуры следует проводить МСКТ с контрастированием. Без введения контраста КТ не информативна.
Чем отличается младенческая гемангиома от капиллярной мальформации?
Гемангиома — это доброкачественная сосудистая опухоль, которая развивается после рождения ребёнка, способна расти и постепенно исчезать. Тогда как капиллярная мальформация — это врождённая сосудистая аномалия, которая появляется уже при рождении. Для неё не характерен пролиферативный рост, отмечается постепенное изменение в цвете.
Иногда гемангиомы возникают при рождении, например врождённые или младенческие гемангиомы. Чтобы отличить их от капиллярной мальформации, ребёнка с сосудистой патологией нужно показать профильному специалисту.

Лечение капиллярной мальформации
Лазерная терапия — основной метод лечения капиллярной мальформации. Она проводится только на селективных лазерах, так как их волны воздействуют исключительно на гемоглобин крови [2] [3] [4] [10] .
Лазерное излучение затрагивает верхние слой капилляров, при котором происходит резкий нагрев эритроцитов. В результате капилляр либо разрывается, либо резко сужается.
Лазерную терапию можно начинать в любом возрасте, но оптимальнее — с 1-го месяца жизни. Если лечение проводится под наркозом, лазерную обработку выполняют в среднем три раза в год, но не больше четырёх. Считается, что для успешной социализации в обществе нужно достичь максимального результата лечения до начала обучения в школе.

Лазерное лечение имеет свои осложнения : временные (обратимые) и постоянные (необратимые). Все они возникают из-за теплового воздействия лазерного излучения на ткани.
Отёк, покраснение и "синячки" относятся к временным осложнениям. Они свидетельствуют об эффективности проведённой процедуры и проходят, как правило, через 7-10 дней после лечения.
Необратимые изменения возникают при чрезмерном воздействии излучения на кожу. Полученный ожог может приводить к появлению рубца . Избежать этих осложнений можно при выборе грамотного специалиста и правильного лазера.
Другим аппаратным методом лечения является IPL — intensivepulselight, т. е. интенсивный импульсный свет. В отличие от лазера, IPL представляет широкополосный свет. По сути, это мощная лампа, для отсечения ненужных диапазонов которой используют специальные фильтры. Такая технология часто используется в косметологии для лечения кожных заболеваний, в том числе для лечения капиллярной мальформации.

До появления лазерных технологий основным методом лечения винных пятен было хирургическое удаление изменённой кожи с пластической коррекцией образовавшегося дефекта. Проводились многочасовые травматичные операции, которые часто оставляли уродующие шрамы, причинявшие больший дискомфорт, чем само пятно.
Склерозирование — ведение лекарственного препарата (склерозанта) через укол — используется при лечении комбинированных мальформаций, например капиллярно-венозной. В лечении простых винных пятен этот метод не используется из-за отсутствия полости, в которую нужно ввести препарат.
Применение бета-адреноблокаторов в виде системной ( пропранолол , атенолол ) или местной терапии ( тимолол , арутимол ) в лечении капиллярной мальформации неэффективно, так как они не действуют на капиллярную ангиодисплазию.
Помимо прочего, сейчас проводятся экспериментальные работы по использованию препарата сиролимуса в качестве системной и местной терапии, но пока широкого применения этот метод не получил.
Прогноз. Профилактика
Как показывают исследования, лазер полностью осветляет только 10-15 % капиллярных мальформаций [11] . В остальных случаях или остаются заметные участки пятна, или лечение совсем не приносит результата. Причина кроется не только в особенностях капиллярной мальформации, но и в нюансах работы лазеров. Однако несмотря на такие цифры, проведённое лечение улучшает качество жизни пациентов [12] .
Специфической профилактики для предупреждения капиллярной мальформации нет. Это врождённый порок развития. У каждого такого пятна есть свои особенности: количество и распределение сосудов в толще кожи, диаметр просвета и преобладание одного типа сосудов над другим. Чтобы лечение было эффективным, врач должен учесть эти нюансы, так как вместе они создают особенности кровоснабжения внутри каждой мальформаций. Иногда доктору удаётся выявить "питающие" сосуды, которые стали причиной неэффективности лазерной коррекции.
Моноизлучение лазеров также имеет свои особенности — определённая длина волны лучше воздействует только на определённую цель. Оператор не может изменить длину волны, но может путём изменения мощности и ширины импульса обработать другие слои кожи. Как показывает опыт, сложнее устранить мелкие капилляры, расположенные у поверхности кожи.
Капиллярная мальформация
Лазерная хирургия — способ проведения хирургических операций, заключающийся в удалении или прижигании небольших участков тканей с минимальным повреждением при помощи лазерного аппарата.
Сосудистая патология
Часть сосудистой патологии является лишь косметическим дефектом, но существуют и сосудистые образования, потенциально угрожающие жизни и здоровью маленького пациента — они требуют активного лечения.
Сосудистая патология у детей разнообразна, она может быть как врождённой, так и приобретённой. Частота встречаемости врожденной сосудистой патологии у детей — от 2% до 10%.
Согласно современным представлениям о сосудистой патологии, все нозологические формы делят на 2 основные группы:
- сосудистые опухоли (гемангиомы);
- пороки развития сосудов (капиллярные мальформации или венозные дисплазии).
Сосудистые опухоли и мальформации могут поражать любой орган и часть тела, но чаще всего сосудистые опухоли встречаются в области головы и шеи, вызывая не только нарушения жизненно важных функций (снижение зрения, ухудшение слуха, нарушения дыхания и глотания, судороги), но и тяжелые эмоциональные страдания.
Послеожоговые рубцы
В детском и подростковом возрасте ожоговая травма — является наиболее частой причиной инвалидизации. В России ежегодно 2000 детей становятся инвалидами вследствие получения травмы. Инвалидность — это не только боль и страдания ребенка, это тяжелый удар для всех членов семьи как в психологическом, так и в финансовом отношении.
Во всем мире отмечается рост количества пациентов детского возраста с последствиями травмы. Так, в России каждые 76 минут погибает один ребёнок, каждые 10 секунд регистрируется одна детская травма, из которых медицинская помощь требуется каждому второму-третьему ребёнку.
В проблеме лечения обширных послеожоговых рубцов можно выделить функциональную и эстетическую составляющие. Функциональная потребность выражается в восстановлении эластичности тканей и подвижности суставов, ограниченных рубцовой тканью, и как результат — возвращение способности к самообслуживанию. Эстетическая потребность выражается в том, что грубые рубцы придают человеку отталкивающий внешний вид, что сказывается на его взаимоотношениях в социуме, особенно среди детей и подростков, а исключение такого ребенка из социума может привести к попыткам самоубийства.
Лечение
Основной задачей в лечении сосудистой патологии является удаление патологических сосудов с помощью лазеров или IPL систем, введения склерозирующих растворов, в тяжелых случаях проводится хирургическое удаление. Чаще всего для эффективного лечения сосудистой патологии применяют сочетание различных методов лечения.
Отличные результаты в лечении сосудистой патологии были получены при применении IPL систем и сосудистых лазеров.Суть методики заключается в том, что лазерный луч без повреждения кожи проникает в глубокие слои мягких тканей и коагулирует патологические сосуды, которые спустя 2–4 месяца перестраиваются в соединительную ткань и исчезают полностью. Период реабилитации короткий, а риск формирования рубцовых изменений на коже минимальный.
В клинической практике во многих случаях подвижность суставов, ограниченная рубцовой тканью, может быть восстановлена корригирующими пластическими операциями. Однако иссечения «проблемных» рубцов не всегда достаточно для достижения необходимого эстетического результата. По своей сути иссечение тоже травма, и в ответ на эту травму снова образуется грубый рубец, больший по размеру. Такие острые для пациента проблемы могут быть решены с помощью инновационной методики лечения — фракционной СО2 лазерной абляции, как в качестве монотерапии, так и в комбинации с хирургическими методами лечения. Данная методика безопасна, может проводиться даже у самых маленьких пациентов, имеет короткий период восстановления и не дает инфекционных осложнений. А результат, полученный от лечения, с течением времени только усиливается.
Медицинские организации
Благотворительный фонд оказывает помощь на базе отделения лазерной хирургии РДКБ ФГБОУ ВО РНИМУ им. Пирогова.
Капиллярная мальформация
Капиллярная мальформация

Пациент с капиллярной
мальформацией лица.
Капиллярная мальформация («винное пятно», «капиллярная ангиодисплазия») — это порок развития сосудов (многослойная сеть сосудов, которая располагается в верхних слоях дермы), представляющий собой плоское сосудистое пятно неправильной формы, ярко-розового, красного и фиолетового цвета. Капиллярные мальформации являются врожденными и не рассасываются самостоятельно. С течением времени они растут пропорционально росту ребёнка. По данным Всемирной организации здравоохранения, около 3% детей появляются на свет с элементами капиллярной мальформации на коже.
Из-за чего возникает капиллярная мальформация?
Основной причиной появления капиллярных мальформаций является дефицит контакта нервных окончаний с определенным участком капиллярной сетки. Данные нервы отвечают за регулировку диаметра кровеносных сосудов, и при дефектах нервных импульсов сосуды не могут полноценно сокращаться, оставаясь расширенными. Поскольку кровеносные сосуды располагаются в непосредственной близости от поверхности кожи, данная патология проявляется в виде фиолетовых, красных и ярко-розовых пятен.
Внешний вид лазера
Vbeam Candela Perfecta.
Как лечат капиллярную мальформацию?
Cамое современное лечение капиллярной мальформации проводится с помощью высокотехнологичного сосудистого лазера, который позволяет всего за несколько процедур значительно уменьшить проявления капиллярной мальформации.
В нашем отделении с этой целью используется лазер на красителях 595 нм Vbeam Candela Perfecta.
Как устроено лечение с помощью лазера?
В основе лечебного лазерного воздействия лежит концепция селективного фототермолиза, которая заключается в лазерном нагревании расширенных сосудов кожи до температуры коагуляции при полном сохранении здоровых окружающих тканей. Такое селективное воздействие на пораженные капилляры позволяет достаточно быстро решить проблемы с патологически расширенными сосудами кожи.
Применение лазера данного вида, при индивидуальном подходе к пациенту, исключает образование рубцов.
Сколько длится лечение капиллярной мальформации?
Лечение лазером является этапным. Подбор параметров работы лазера всегда происходит индивидуально для каждого ребёнка. В среднем, количество этапов, которые должен пройти пациент, составляет от 6 до 8 и зависит от степени выраженности капиллярной мальформации, её площади и типа кожи ребёнка.
Внешний вид пациента: до лечения, после 1 этапа и после 2 этапа обработки лазером.
Необходимо ли обезболивание при проведении данного вида лечения?
В нашем отделении лечатся дети с капиллярными мальформациями, располагающимися в челюстно-лицевой области. Учитывая сложную анатомическую структуру (веки, крылья, кончик и преддверие носа, губы, ушные раковины), адекватно провести лазерную обработку без должного обезболивания невозможно. С целью обезболивания применяется ингаляционный аппаратно-масочный наркоз препаратом «Севоран». Обычно длительность наркоза составляет не более 15 мин.
Когда нужно начинать лечение капиллярной мальформации?
Долгое время капиллярная мальформация расценивалась в медицине исключительно как косметологическая проблема. Однако доказано, что данная патология зачастую создает выраженную психологическую напряженность в семье, мешает ребенку полноценно социализироваться в обществе. Решение о начале лечения принимается индивидуально в каждом конкретном случае. Стоит отметить, что завершить лечение, по возможности, необходимо до 6-7 летнего возраста ребёнка. Именно в этом возрасте ребёнок начинает понимать, что с его внешним видом что-то не так — он «не похож» на окружающих. В дальнейшем это может стать психологической травмой для него и оказать сильное влияние на формирование его личности.
Как попасть к нам на лечение?
Читайте также:
- Циклотимическое расстройство
- МРТ при постлучевой плексопатии
- Врожденная гладкомышечная гамартома. Диффузная гладкомышечная гамартома. Поперечнополосатые гамартромы.
- Бесплодие при гиперпролактинемии, иммуннитете к сперме и микоплазмах
- Мелкоочаговый инфаркт при алкоголизме. Алкогольная кардиопатия при инфаркте
